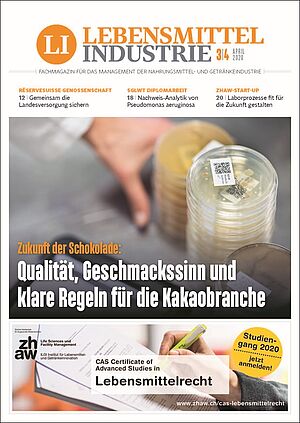
April 3/4 2020

all about automation
Fachmesse für Industrieautomation
Datum: 26.-27. August 2026
Ort: Zürich (CH)
INTERVIEW
Zukunft der Schokolade – Qualität, Geschmackssinn und klare Regeln für die Kakaobranche
ORGANISATION + WIRTSCHAFT
réservesuisse genossenschaft – Gemeinsam die Landesversorgung sichern
PRODUKTION + TECHNIK
Forschungspreise für die Bio-Praxis – «Herausragende Arbeiten» für die gesamte Branche
Nachweis-Analytik von Pseudomonas aeruginosa – Diplomarbeit mit SGLWT-Preisauszeichnung
ZHAW-Start-up 1LIMS – Laborprozesse fit für die Zukunft gestalten
Food Architecture – Mehr Wertigkeit, weniger Marketing
Fallstudie Logistik und Prozessautomation – Ein Bonbon geht um die Welt
Anlagen- und Apparateunterhalt lebensmittelverträglich gestalten
Verpackung in Krisenzeiten – wichtiger Beitrag zur Versorgungssicherheit
RUBRIKEN
Hors d'oeuvre
Carte Blanche Krise als Chance zur Rückbesinnung auf unsere Werte
Aus dem Fial-Newsletter Agrarpolitik 22+
Fachmesse für Industrieautomation
Datum: 26.-27. August 2026
Ort: Zürich (CH)
Networking. Forum. Aussteller
Datum: 23.-24. September 2026
Ort: Lausanne (CH)
Weltleitmesse der Kältetechnik
Datum: 13.-15. Oktober 2026
Ort: Nürnberg (D)
Fachmesse für Nahrungsmittel-Innovationen
Datum: 17.-21. Oktober 2026
Ort: Paris (F)
Weltleitmesse und Konferenz der Elektronik
Datum: 10.-13. November 2026
Ort: München (D)
The global marketplace for Packaging Processing Printing Handling
Datum: 23.-26. November 2026
Ort: Paris (F)
Internationale Zuliefermesse für die Lebensmittel- und Getränkeindustrie
Datum: 23.-26. März 2027
Ort: Köln (D)
Internationale Leitmesse der Prozessindustrie
Datum: 14.-18. Juni 2027
Ort: Frankfurt am Main (D)
Weltweit führende Fachmesse für Drucktechnologien
Datum: 09.-17. Mai 2028
Ort: Düsseldorf (D)